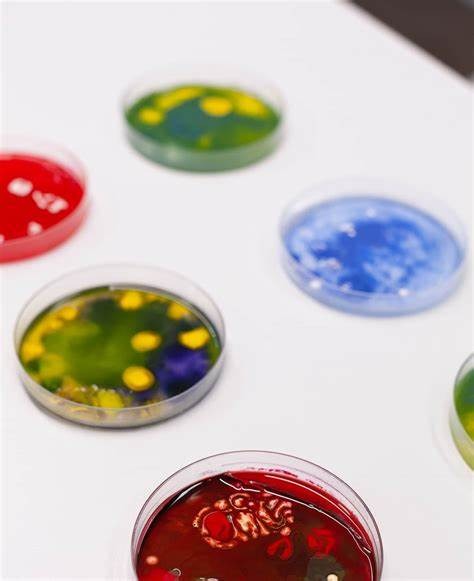
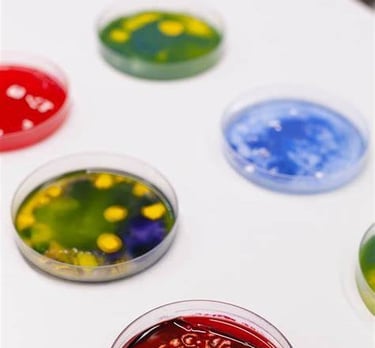

Instalaciones y Prácticas
Nuestras instalaciones educativas están diseñadas para ofrecer un entorno de aprendizaje moderno y funcional, ideal para la formación de futuros asistentes clínicos. Desde el momento en que ingresas, te recibirán espacios amplios y bien iluminados, equipados con tecnología de vanguardia que facilita una experiencia educativa integral.
Educar a una persona no es hacerle aprender algo que no sabía, sino hacer de él alguien que no existía.
Aulas Interactivas
Contamos con aulas equipadas con tecnología multimedia, pizarras para tu aprendizaje y recursos didácticos que fomentan la participación activa de los estudiantes. El diseño de nuestras aulas permite la flexibilidad en la disposición del mobiliario, favoreciendo tanto el trabajo en grupo como las actividades individuales.







Salas de Simulación
Disponemos de salas de simulación donde los estudiantes pueden enfrentar situaciones clínicas reales a través de escenarios prácticos. Estas experiencias son cruciales para desarrollar habilidades críticas como la comunicación, el trabajo en equipo y la toma de decisiones bajo presión.






Prácticas
El Auxiliar en Enfermería es un profesional clave en el ámbito sanitario, brindando apoyo a enfermeros y médicos en el cuidado de los pacientes. Sus tareas principales incluyen:
Atención al paciente:
Apoyar en la higiene y confort de los pacientes.
Asegurar el bienestar y comodidad del paciente durante su estancia.
Procedimientos médicos:
Tomar signos vitales y registrar datos clínicos.
Administrar medicamentos bajo la supervisión de un enfermero o médico.
Colaborar en procedimientos médicos y terapéuticos.
Prevención y control de infecciones:
Aplicar medidas de asepsia y antisepsia.
Conocer microorganismos y su impacto en enfermedades infecciosas.
Seguir protocolos de seguridad sanitaria.
Trabajo en equipo y formación:
Coordinar con enfermeros y médicos para garantizar el seguimiento del tratamiento.
Utilizar herramientas digitales (ej. plataformas 3D) para mejorar el aprendizaje en anatomía y microbiología.
Mantener una actitud empática y paciente con los pacientes y sus familias.


"Educar no es enseñar al hombre a saber, sino a hacer. Nunca digas ni aceptes excusas."
En CLITH ATP, nuestro objetivo principal es formar profesionales de la salud competentes y bien preparados, capaces de enfrentar los desafíos clínicos con conocimientos sólidos y habilidades prácticas. Para ello, integramos enfoques innovadores que promueven un aprendizaje activo y colaborativo, como el uso de una plataforma 3D interactiva que facilita la comprensión de la anatomía humana. Además, fortalecemos la formación en microbiología, brindando a los estudiantes las herramientas necesarias para identificar, clasificar y comprender el papel de los microorganismos en las enfermedades infecciosas, fomentando así una preparación integral en la prevención, control y asistencia en tratamientos dentro del entorno clínico.

Formando manos que cuidan con vocación
En esta galería te presentamos una mirada al compromiso, dedicación y aprendizaje de nuestros alumnos de enfermería auxiliar durante sus prácticas profesionales. A través de cada imagen, se refleja el esfuerzo diario por adquirir habilidades clínicas, fortalecer el trabajo en equipo y brindar atención humanizada. Estas experiencias son clave en su formación, preparando a cada estudiante para enfrentar los retos del entorno de salud con empatía y profesionalismo.








Formación Profesional en Salud de Alta Calidad.
CLITH


Síguenos en nuestras redes sociales
ATP

